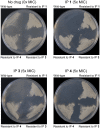

Identification of novel imidazo[1,2-a]pyridine inhibitors targeting M. tuberculosis QcrB
- PMID: 23300833
- PMCID: PMC3534098
- DOI: 10.1371/journal.pone.0052951
Identification of novel imidazo[1,2-a]pyridine inhibitors targeting M. tuberculosis QcrB
Abstract
Mycobacterium tuberculosis is a major human pathogen and the causative agent for the pulmonary disease, tuberculosis (TB). Current treatment programs to combat TB are under threat due to the emergence of multi-drug and extensively-drug resistant TB. Through the use of high throughput whole cell screening of an extensive compound library a number of imidazo[1,2-a]pyridine (IP) compounds were obtained as potent lead molecules active against M. tuberculosis and Mycobacterium bovis BCG. The IP inhibitors (1-4) demonstrated minimum inhibitory concentrations (MICs) in the range of 0.03 to 5 µM against a panel of M. tuberculosis strains. M. bovis BCG spontaneous resistant mutants were generated against IP 1, 3, and 4 at 5× MIC and subsequent whole genome sequencing identified a single nucleotide polymorphism (937)ACC>(937)GCC (T313A) in qcrB, which encodes the b subunit of the electron transport ubiquinol cytochrome C reductase. This mutation also conferred cross-resistance against IP 1, 3 and 4 demonstrating a common target. Gene dosage experiments confirmed M. bovis BCG QcrB as the target where over-expression in M. bovis BCG led to an increase in MIC from 0.5 to >8 µM for IP 3. An acute murine model of TB infection established bacteriostatic activity of the IP series, which await further detailed characterization.
Conflict of interest statement
Figures

References
-
- Yew WW, Sotgiu G, Migliori GB (2012) Update in tuberculosis and nontuberculous mycobacterial disease 2010. Am J Respir Crit Care Med 184: 180–185. - PubMed
-
- Dye C, Williams BG (2010) The population dynamics and control of tuberculosis. Science 328: 856–861. - PubMed
-
- Koul A, Arnoult E, Lounis N, Guillemont J, Andries K (2011) The challenge of new drug discovery for tuberculosis. Nature 469: 483–490. - PubMed
-
- Chiang CY, Centis R, Migliori GB (2010) Drug-resistant tuberculosis: past, present, future. Respirology 15: 413–432. - PubMed
Publication types
MeSH terms
Substances
LinkOut - more resources
Full Text Sources
Other Literature Sources
Medical

